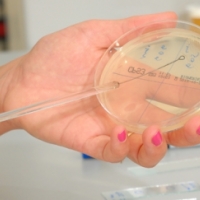

Лекари
Информация
Диагностично – консултативен център „Александровска” осигурява свободен и разширен достъп на пациентите до специалистите на Университетска болница „Александровска”, голяма част от които са хабилитирани щатни служители на болницата с по две и повече клинични специалности (основна и профилни). По-голямата част от кабинетите са разположени в сградата на центъра, други, поради спецификата на заболяванията, са разкрити към някои от профилираните клиники – алергология, детски болести, психиатрия, хирургия, урология и др.
Услуги
Диагностично – консултативен център „Александровска” има разрешение за оказване на високоспециализирана диагностично – консултативна доболнична помощ по следните специалности:
- Алергология
- Вътрешни болести
- Гастроентерология
- Детски болести
- Детски очен кабинет
- Диететика
- Ендокринология
- Ехографски кабинет
- Кардиология
- Кожни и венерически болести
- Лечение на болката и иглотерапия
- Неврология, психология, невропсихология
- Неврохирургия
- Нефрология
- Очни болести
- Психиатрия
- Пулмология
- УНГ
- Урология
- Физиотерапия и рехабилитация
- Хематология
- Хирургия
Промоции / Акцент
В ДКЦ „Александровска” се извършва диспансеризация на определени контингенти, експертиза на работоспособността и други медико-биологични инструментални изследвания и дейности.
Центърът разполага с обща ЛКК и специализирана ЛКК по хирургия, които осигуряват продължителен домашен отпуск на пациентите за лечение и възстановяване.
Извършват се и профилактични прегледи, съгласно изискванията на службите по трудова медицина.
Прегледи и изследвания на пациенти без направления за специалист, както и на здравно неосигурените лица, се извършват в ДКЦ „Александровска” срещу заплащане според ценовата листа на здравните услуги на центъра.
Оборудване
Центърът разполага с високоспециализирана апаратура за диагностично уточняване - ядрено-магнитен резонанс, компютърен томограф, ехограф, ехокардиограф, остеометър, доплер-сонограф, мамограф, дерматоскоп, компютърен рефрактометър, апарат за уродинамични изследвания и диагностика, холтери (за ЕКГ и за кръвно налягане).
Изследвания
ДКЦ „Александровска” има сключен договор със Здравната каса за извършване на консултативни прегледи, клинико-лабораторни, рентгенови, патоанатомични, микробиологични и имунологични изследвания, тестуване с алергени, физиотерапевтични и други здравни услуги.